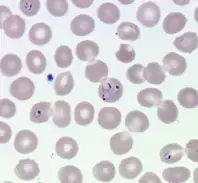
Malariaparasiter sedda i ett mikroskop.

Vår forskargrupp
Christopher Sundling har ett eget team med fokus på inflammation och immunreglering vid infektion, speciellt tuberkulos och malaria. Katja Wyss arbetar med kliniska aspekter, inklusive diabetes och malaria i Kamerun. Victor Yman om seroepidemiologi och övervakning av vektorburna infektioner; och Klara Sondén med att förbättra handläggningen av tropisk feber.
Flera läkare leder sina egna projektgrupper och doktorander, inklusive Judith Bruchfeld arbetar med tuberkulos och post-covid, Lina Davies Forsman med multiresistent tuberkulos, Ann Tammelin om vårdrelaterade infektioner och Helena Hervius Askling med kliniska prövningar av vaccin.
Vår forskning om malaria
Malaria är ett stort globalt hälsoproblem. Nya verktyg behövs för att minska den stora sjukligheten och dödligheten i malaria. Utveckling av ett effektivt vaccin mot malaria kräver förståelse för hur man kan bli och förbli immun mot malaria. Vår grupp är särskilt intresserad av mångfalden av parasitstammar och antigenvarianter som parasiten utvecklat för att undkomma immuniteten. Vårt mål är att identifiera antigener som kan ingå i ett mer effektivt malariavaccin. Vi önskar även förstå mekanismerna för hur immunitet mot malaria förvärvas och upprätthålls. I studier av resenärer som framgångsrikt behandlats för malaria i Sverige och sedan följs över tid, har vi möjlighet att studera immunsvaret utan risk för nya infektioner. Vi studera immunologiskt minne i samband med malaria såväl som andra infektioner.
I syfte att förbättra den kliniska handläggningen av malaria har vi etablerat en nationell studie av de akuta och långsiktiga effekterna av malaria hos resenärer och migranter. Vi är även intresserade av asymtomatiska infektioner, och utbredning och hälsoeffekter av bäraraskap av malariaparasiter och andra parasiter hos migranter, och behovet av att införa screening.
